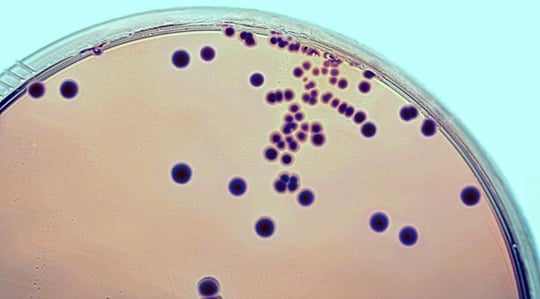
Gram-positive

DISINFACTS
Stay updated on hygiene and infection protection with our comprehensive DISINFACTS periodical. Explore new recommendations, regulations, studies, products, and expert knowledge on diseases and active ingredients. Register now for the online package.
Learn more